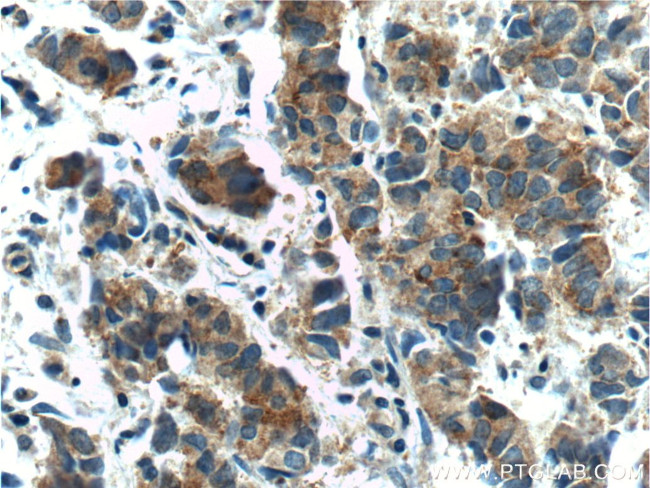
TMPRSS2 Antibody in Immunohistochemistry (Paraffin) (IHC (P))

Search
Proteintech
TMPRSS2 Polyclonal Antibody
{{$productOrderCtrl.translations['antibody.pdp.commerceCard.promotion.promotions']}}
{{$productOrderCtrl.translations['antibody.pdp.commerceCard.promotion.viewpromo']}}
{{$productOrderCtrl.translations['antibody.pdp.commerceCard.promotion.promocode']}}: {{promo.promoCode}} {{promo.promoTitle}} {{promo.promoDescription}}. {{$productOrderCtrl.translations['antibody.pdp.commerceCard.promotion.learnmore']}}
产品信息
14437-1-AP
种属反应
已发表种属
宿主/亚型
分类
类型
抗原
偶联物
形式
浓度
规格
纯化类型
保存液
内含物
保存条件
运输条件
产品详细信息
Immunogen sequence: FMGSKCSNS GIECDSSGTC INPSNWCDGV SHCPGGEDEN RCVRLYGPNF ILQVYSSQRK SWHPVCQDDW NENYGRAACR DMGYKNNFYS SQGIVDDSGS TSFMKLNTSA GNVDIYKKLY HSDACSSKAV VSLRCIACGV NLNSSRQSRI VGGESALPGA WPWQVSLHVQ NVHVCGGSII TPEWIVTAAH CVEKPLNNPW HWTAFAGILR QSFMFYGAGY QVEKVISHPN YDSKTKNNDI ALMKLQKPLT FNDLVKPVCL PNPGMMLQPE QLCWISGWGA TEEKGKTSEV LNAAKVLLIE TQRCNSRYVY DNLITPAMIC AGFLQGNVDS CQGDSGGPLV TSKNNIWWLI GDTSWGSGCA KAYRPGVYGN VMVFTDWIYR QMRADG (108-492 aa encoded by BC051839)
靶标信息
TMPRSS2 is a protein that belongs to the serine protease family. The protein contains a type II transmembrane domain, a receptor class A domain, a scavenger receptor cysteine-rich domain and a protease domain. Serine proteases are known to be involved in many physiological and pathological processes. Its gene was demonstrated to be up-regulated by androgenic hormones in prostate cancer cells and down-regulated in androgen-independent prostate cancer tissue. The protease domain of this protein is thought to be cleaved and secreted into cell media after autocleavage.
仅用于科研。不用于诊断过程。未经明确授权不得转售。
生物信息学
蛋白别名: EC 3.4.219; Epitheliasin; FLJ41954; MGC6821; Plasmic transmembrane protein X; proteinase; Serine protease 10; TMPS2; Transmembrane protease serine 2; transmembrane protease, serine 2; unnamed protein product
基因别名: D16Ertd61e; PRSS10; TMPRSS2
UniProt ID: (Human) O15393, (Mouse) Q9JIQ8
Entrez Gene ID: (Human) 7113, (Mouse) 50528, (Rat) 156435